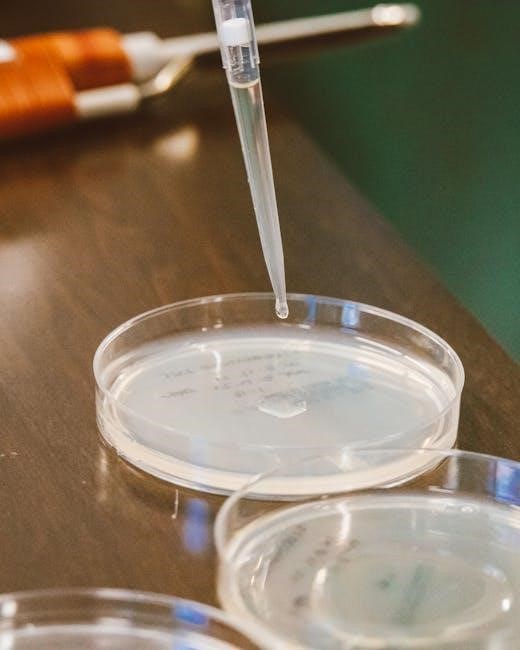

What is Pilates? A Beginner’s Guide
Pilates is gaining traction, with resources like PDF guides and online classes making it accessible; it focuses on core strength, flexibility, and controlled movements.
Many beginners are exploring Pilates through downloadable PDF workouts, offering a convenient way to start from home and build a solid foundation.
Pilates isn’t about speed, but precision; PDF resources often detail proper form, helping newcomers avoid injury and maximize benefits, like improved posture.
The History and Principles of Pilates
Pilates, originally called “Contrology,” was developed by Joseph Pilates in the early 20th century. He designed the method to rehabilitate individuals during and after World War I, focusing on strengthening the body and mind. PDF guides for beginners often highlight these foundational principles.
Central to Pilates are six core principles: concentration, control, centering, precision, breath, and flow. These aren’t just abstract ideas; beginner PDFs demonstrate how to apply them during exercises. Concentration ensures mindful movement, while control prevents injury. Centering emphasizes engaging the core, and precision focuses on quality over quantity.
Breathwork is integral, coordinating with movements to enhance stability and efficiency. Flow creates a seamless sequence, building strength and flexibility. Many introductory Pilates PDF resources break down these principles, offering modifications for varying fitness levels, making it accessible to everyone.
Pilates vs. Yoga: Key Differences
While both Pilates and Yoga emphasize mind-body connection, they differ in approach. Yoga often incorporates spiritual elements and holding poses, while Pilates focuses on core strength, precise movements, and rehabilitation. Beginner PDFs often clarify these distinctions.
Pilates emphasizes strengthening the “powerhouse” – the core muscles – to support the spine and improve posture. Yoga, conversely, often prioritizes flexibility and balance. Many introductory Pilates PDFs highlight exercises specifically targeting core engagement.
Breathwork differs too; Yoga utilizes various breathing techniques (pranayama), while Pilates emphasizes lateral thoracic breathing. Choosing between the two depends on individual goals. PDF resources can help beginners understand which aligns better with their needs, offering modified exercises for all levels.

Benefits of Pilates for Beginners
Pilates offers numerous benefits, including improved core strength, flexibility, and posture; beginner PDF guides demonstrate accessible exercises for all fitness levels.
Starting with Pilates can enhance body awareness and provide a low-impact workout; downloadable PDFs offer structured routines for safe and effective practice.
Pilates is quickly becoming popular, with many finding success using PDF resources to learn proper form and build a strong foundation at their own pace.
Improved Core Strength
Pilates fundamentally focuses on strengthening the core, encompassing deep abdominal muscles, back muscles, and pelvic floor. This isn’t just about achieving a “six-pack”; it’s about building a stable center for all movement. Beginner Pilates PDF resources often prioritize exercises like The Hundred, Roll-Ups, and Leg Pull Front, progressively challenging these core muscles.
These PDF guides break down each exercise with detailed instructions and modifications, ensuring proper form to maximize effectiveness and prevent injury. Strengthening the core through Pilates improves posture, balance, and overall functional fitness. Many PDFs emphasize engaging the “powerhouse” – a key Pilates principle – throughout each exercise, fostering a deeper connection to core muscles.
Consistent practice, guided by beginner Pilates PDFs, leads to noticeable improvements in core stability, making everyday activities easier and reducing the risk of back pain.
Increased Flexibility and Mobility
Pilates emphasizes controlled movements through a full range of motion, significantly enhancing flexibility and mobility. Beginner Pilates PDFs often include exercises like Single Leg Circles, Spine Stretch Forward, and Rolling Like a Ball, designed to gently lengthen muscles and improve joint articulation. These exercises aren’t about forcing flexibility, but rather encouraging it through mindful movement.
PDF guides typically provide modifications for varying flexibility levels, making Pilates accessible to everyone. Increased flexibility reduces muscle tension, improves posture, and enhances athletic performance. The focus on spinal articulation, detailed in many PDFs, promotes a healthy spine and reduces the risk of injury.
Regular practice, utilizing beginner Pilates PDF resources, leads to noticeable improvements in range of motion and a greater sense of ease in movement.
Enhanced Posture and Body Awareness
Pilates cultivates a deep connection between mind and body, leading to enhanced posture and body awareness. Beginner Pilates PDFs frequently emphasize core engagement and spinal alignment, foundational elements for good posture. Exercises like The Hundred and Leg Pull Front, detailed in these guides, strengthen the muscles that support the spine.
Through precise movements, Pilates encourages individuals to become more attuned to their body’s positioning and movement patterns. PDF resources often include cues to maintain proper form, promoting mindful movement and preventing imbalances. This heightened awareness translates into improved posture in daily life.
Consistent practice with beginner Pilates PDFs helps correct postural habits and build a stronger, more balanced physique, fostering a greater sense of body control.
Low-Impact Exercise for All Fitness Levels
Pilates is renowned as a low-impact exercise method, making it accessible to individuals of all fitness levels. Beginner Pilates PDFs often feature modifications for each exercise, catering to varying strengths and limitations. This adaptability ensures a safe and effective workout, regardless of prior experience.
Unlike high-intensity activities, Pilates minimizes stress on joints, reducing the risk of injury. PDF guides typically demonstrate exercises with clear instructions and visual aids, promoting proper form and preventing strain. This gentle approach is particularly beneficial for seniors or those recovering from injuries.
Whether you’re a seasoned athlete or just starting your fitness journey, beginner Pilates PDFs provide a foundation for building strength, flexibility, and body awareness.

Essential Pilates Equipment (and What You Don’t Need)
Pilates often utilizes specialized equipment, but many beginner PDF workouts require none! Mat Pilates, detailed in downloadable guides, is a fantastic starting point.
While reformers and Cadillac tables exist, accessible Pilates PDFs demonstrate effective exercises using just your bodyweight and perhaps small props.
The Reformer: An Overview
The Pilates Reformer is a bed-like frame with a flat platform that rolls forward and backward on wheels. It uses springs for resistance, offering a versatile workout. While intimidating initially, understanding its components is key.
PDF guides focusing on beginner Pilates often don’t heavily feature the Reformer, as it’s more advanced. However, some introductory materials will illustrate basic Reformer exercises.
The footbar, headrest, and straps are adjustable, allowing for varied exercises targeting different muscle groups. Exercises on the Reformer emphasize core engagement, spinal alignment, and controlled movements.
Beginners might encounter exercises like footwork, which builds leg strength and core stability, or short spine massage, promoting spinal mobility. Accessing Pilates exercises for beginners PDF resources can help visualize these movements before trying them on the machine.
Ultimately, the Reformer enhances Pilates principles, but isn’t essential for starting your journey.
Cadillac/Trapeze Table Explained
The Cadillac, also known as the Trapeze Table, is a more advanced Pilates apparatus featuring a frame with a raised platform and a trapeze bar suspended above. It offers a wider range of exercises than the Reformer, utilizing springs for variable resistance.
Pilates exercises for beginners PDF materials rarely focus on the Cadillac due to its complexity and the need for experienced instruction. It’s generally not a starting point for newcomers.
The Cadillac allows for exercises in various positions – lying down, sitting, kneeling, and standing – challenging core strength, flexibility, and coordination. Exercises often involve the trapeze bar, push-through bar, and roll-down bar.
Common movements include roll-overs, spinal twists, and leg pulls, requiring significant control and body awareness. While PDF guides may briefly mention it, practical experience with a qualified instructor is crucial.
The Cadillac is a powerful tool for rehabilitation and advanced Pilates practice.
Mat Pilates: Your Starting Point
Mat Pilates is the most accessible form of Pilates, requiring minimal equipment – just a mat! This makes it ideal for beginners and a common focus of Pilates exercises for beginners PDF guides.
Numerous free and paid PDF resources detail foundational mat exercises, like the Hundred, Roll-Ups, and Single Leg Circles, building core strength and body awareness.
These guides often include modifications for different fitness levels, ensuring exercises are challenging yet achievable. Emphasis is placed on proper form and controlled movements.
Mat Pilates strengthens the core, improves flexibility, and enhances posture without stressing joints. It’s a low-impact workout suitable for all ages and fitness levels.
Starting with Mat Pilates provides a solid base before progressing to apparatus-based Pilates, like the Reformer or Cadillac.
Small Props: Resistance Bands & Pilates Balls
Pilates doesn’t always require expensive equipment; small props like resistance bands and Pilates balls can significantly enhance your workout, and are often featured in Pilates exercises for beginners PDF guides.
Resistance bands add challenge to exercises, increasing muscle engagement and improving strength. PDFs demonstrate how to incorporate them into classic Pilates moves.
Pilates balls introduce instability, forcing core muscles to work harder for balance and control. They’re excellent for improving posture and spinal alignment.
Many beginner PDFs offer exercises specifically designed for these props, providing a progressive approach to building strength and stability.
These affordable props make Pilates more versatile and accessible, allowing you to modify exercises to suit your fitness level and goals.

Getting Started: A Beginner Pilates Routine
Pilates routines for beginners are readily available as PDFs, offering structured workouts; start with foundational exercises and gradually increase intensity for optimal results.
Warm-Up Exercises (5-10 minutes)
Before diving into a Pilates routine, a proper warm-up is crucial to prepare your muscles and joints, minimizing the risk of injury. Many beginner Pilates PDF guides emphasize the importance of gentle movements to increase blood flow and flexibility.
Begin with 5-10 minutes of simple exercises like gentle neck rotations, shoulder circles, and arm stretches. Incorporate pelvic tilts to engage your core and prepare your spine for movement; Leg swings and ankle rotations will warm up your lower body.
PDF resources often include detailed instructions and illustrations for these warm-up exercises, ensuring correct form. Focus on controlled breathing throughout the warm-up, coordinating your breath with each movement. This prepares both your body and mind for the more challenging exercises to come, setting the stage for a successful Pilates session.
The Hundred: A Core Foundation
The Hundred is a classic Pilates exercise, often featured prominently in beginner PDF workout guides, designed to build core strength and endurance. It’s a foundational exercise that challenges your abdominal muscles while improving breathing control.
Typically, you start lying on your back with knees bent and feet flat on the floor. Curl your head and shoulders off the mat, reaching your arms long by your sides. Pump your arms up and down while inhaling for five counts and exhaling for five counts, repeating this cycle 10 times – hence “The Hundred.”
PDF resources often offer modifications for beginners, such as keeping the head down or knees bent. Mastering this exercise requires focus and precision, establishing a strong core connection for more advanced Pilates movements.
Roll-Ups: Building Spinal Articulation
Roll-Ups are a progressive Pilates exercise frequently included in beginner PDF guides, focusing on strengthening the core and improving spinal mobility. This exercise teaches controlled movement, emphasizing articulation throughout the spine rather than relying on momentum.
Begin lying flat on your back with legs extended and arms reaching overhead. Inhale to prepare, then exhale as you slowly curl your chin to your chest and roll up one vertebra at a time, reaching towards your toes. Inhale at the top, then exhale as you slowly roll back down, maintaining control.
PDF resources often suggest modifications, like bending the knees or using arms to assist, for those new to the exercise. Mastering Roll-Ups builds core strength and enhances body awareness.
Single Leg Circles: Hip Mobility
Single Leg Circles are a foundational Pilates exercise often detailed in beginner PDF workout plans, designed to enhance hip mobility and core stability. This exercise promotes controlled movement of the leg while maintaining a stable pelvis and spine.
Begin lying on your back with one leg extended towards the ceiling and the other bent with the foot flat on the floor. Keeping the extended leg straight (a slight bend is okay), draw small circles with your foot, maintaining core engagement.
PDF guides emphasize keeping the hips stable and avoiding rocking. Reverse the direction of the circles. This exercise improves hip joint range of motion and strengthens the deep core muscles.
Rolling Like a Ball: Spinal Massage
Rolling Like a Ball is a playful yet effective Pilates exercise frequently found in beginner PDF routines, offering a gentle spinal massage and core strengthening benefits. It challenges balance and coordination while promoting spinal articulation.
Begin seated with knees bent into your chest, holding onto your shins. Round your spine into a “C” curve and gently roll back onto your shoulders, then back up to the seated position.
PDF resources stress maintaining a tight core and avoiding rolling onto your neck. This exercise improves spinal mobility, strengthens abdominal muscles, and provides a soothing massage to the spine. Focus on control and breath throughout the movement.
Spine Stretch Forward: Lengthening the Spine
Spine Stretch Forward is a foundational Pilates exercise often detailed in beginner PDF guides, designed to increase spinal flexibility and promote a lengthened spine; It emphasizes controlled movement and deep breathing to enhance body awareness.
Begin seated with legs extended forward, feet flexed. Inhale to prepare, then exhale as you reach forward, rounding your spine and drawing your abdominals inward. Keep your sit bones grounded and maintain a gentle curve in your spine.
PDF instructions often highlight the importance of avoiding strain and focusing on reaching with your breath, not just your hands. This exercise improves posture, relieves tension, and strengthens core muscles.
Swan Dive: Back Extension
Swan Dive, a classic Pilates exercise frequently illustrated in beginner PDFs, focuses on strengthening the back muscles and improving spinal mobility. It’s crucial to approach this exercise with controlled movements and proper form to prevent injury.
Begin lying prone with hands placed under your shoulders, elbows bent. Inhale to prepare, then exhale as you lift your chest off the mat, using your back muscles – not just your hands. Keep your shoulders down and neck long.
PDF guides emphasize engaging the core throughout the movement and avoiding hyperextension of the lower back. This exercise enhances posture, counteracts slouching, and builds a strong, supple spine.
Leg Pull Front: Core and Shoulder Stability
Leg Pull Front, often detailed in beginner Pilates PDFs, is a challenging yet rewarding exercise that builds core strength, shoulder stability, and overall body control. It requires significant coordination and mindful engagement of multiple muscle groups.

Starting in a plank position, with hands directly under shoulders, walk your feet towards your hands while simultaneously lifting your hips towards the ceiling. Maintain a straight line from head to heels, actively pressing into the hands.
PDF resources highlight the importance of keeping the core engaged to prevent sagging and maintaining shoulder protraction to protect the shoulder joints. This exercise improves posture and functional strength.

Pilates for Specific Needs
Pilates adapts well to individual needs; PDF guides offer modifications for back pain, postpartum recovery, seniors, and athletes, ensuring safe and effective practice.
Pilates for Back Pain
Pilates offers a gentle yet effective approach to managing and alleviating back pain, focusing on core stabilization and spinal alignment. Many PDF resources specifically cater to individuals with back issues, providing modified exercises and progressions.
These Pilates for back pain PDF guides often emphasize exercises like pelvic tilts, bird-dog, and gentle spinal twists, designed to strengthen supporting muscles without exacerbating discomfort. It’s crucial to start with beginner-level routines and prioritize proper form over the number of repetitions.
Look for PDFs that detail how to engage the core muscles – the “powerhouse” – to protect the spine during movement. Avoid exercises that involve excessive forward flexion or twisting if you have acute back pain, and always consult with a healthcare professional before starting any new exercise program.

Pilates for Postpartum Recovery
Pilates is a fantastic option for postpartum recovery, gently rebuilding core strength and addressing common changes after childbirth. Numerous PDF guides are tailored to new mothers, offering safe and effective exercises for each stage of recovery.
These Pilates for postpartum PDFs typically begin with gentle breathing exercises and pelvic floor activations, crucial for restoring pelvic health. Progressing to exercises like pelvic tilts, heel slides, and modified planks helps rebuild core stability without putting excessive strain on the abdominal muscles.
Always prioritize diastasis recti assessment and modification, as indicated in many PDF resources. Listen to your body, avoid pushing through pain, and consult with a healthcare professional or qualified Pilates instructor before starting any postpartum exercise routine.
Pilates for Seniors
Pilates offers a gentle yet effective way for seniors to maintain mobility, improve balance, and enhance overall well-being. Many readily available PDF guides specifically cater to the needs of older adults, providing modified exercises for varying fitness levels.
These Pilates for seniors PDFs often emphasize chair-based exercises, making them accessible for individuals with limited mobility. Focus is placed on controlled movements, strengthening core muscles, and improving posture, all crucial for preventing falls and maintaining independence.
Exercises like seated marches, arm circles, and gentle spinal twists are commonly included. Remember to consult a healthcare professional before starting any new exercise program, and prioritize proper form as detailed in the PDF guides.
Pilates for Athletes
Pilates is increasingly recognized as a valuable cross-training method for athletes, enhancing performance and reducing injury risk. While advanced routines exist, even beginner Pilates exercises – often detailed in accessible PDF guides – can provide significant benefits.
These PDF resources focus on core stabilization, which is fundamental to power transfer and efficient movement in any sport. Exercises like the “hundred” and roll-ups build core strength, while single leg circles improve hip mobility and balance.
Athletes can utilize these foundational Pilates movements to improve body awareness, correct muscle imbalances, and enhance recovery. Integrating Pilates, even through beginner PDF workouts, can contribute to a more resilient and well-rounded athletic physique.

Finding Pilates Resources
Pilates resources abound online, including numerous PDF guides offering beginner workouts; apps and videos supplement these, providing visual instruction and structured routines.
Many free PDF charts detail exercises, while comprehensive guides offer deeper insights into Pilates principles and progression for all fitness levels.
Online Pilates Classes & Videos
Pilates has experienced a surge in online accessibility, offering a wealth of classes and videos perfect for beginners seeking to supplement PDF workout guides. Platforms like YouTube host channels dedicated to Pilates, often featuring introductory routines and form tutorials.
Many instructors provide free content, allowing you to sample their teaching style before committing to a paid subscription. Paid platforms offer structured programs, often categorized by skill level, ensuring a progressive learning experience. When utilizing online resources alongside PDFs, prioritize videos demonstrating proper technique to avoid injury.
Look for instructors who emphasize core engagement, spinal articulation, and controlled movements – key principles of Pilates. Remember to listen to your body and modify exercises as needed, especially when starting. Combining visual learning with downloadable PDFs creates a well-rounded approach to mastering Pilates fundamentals.
Pilates Apps for Home Workouts
Pilates apps provide a convenient and structured way to practice at home, often complementing downloadable PDF workout plans. These apps frequently offer guided routines, progress tracking, and modifications for various fitness levels, making them ideal for beginners. Many apps feature video demonstrations, reinforcing proper form learned from PDF guides.
Subscription-based apps typically unlock a wider range of workouts and personalized programs, while free options offer a taste of what’s available. Look for apps that emphasize core engagement and controlled movements, mirroring the principles outlined in beginner Pilates PDFs.
Some apps allow you to create custom workouts, integrating exercises from your PDF resources. Utilizing both apps and PDFs provides a dynamic learning experience, fostering consistency and helping you build a strong Pilates foundation.
Finding a Qualified Pilates Instructor
Pilates, while accessible through PDFs and online resources, truly flourishes under the guidance of a certified instructor. A qualified instructor ensures proper form, preventing injuries and maximizing the benefits of each exercise. They can personalize routines based on your individual needs and goals, supplementing what you learn from PDF guides.
Look for instructors certified by reputable organizations, demonstrating a commitment to quality instruction. Initial consultations allow you to discuss your fitness level and any physical limitations, ensuring a safe and effective program.
An instructor can refine your technique, addressing nuances often missed when self-teaching with PDFs. They’ll help you progress safely, building upon the foundational exercises detailed in beginner Pilates resources, ultimately enhancing your practice.

Pilates PDF Resources for Beginners
Pilates PDFs offer accessible workouts, detailing exercises for all levels; they’re ideal for beginners seeking structured routines and form guidance at home.
Free Printable Pilates Charts
Pilates beginners often benefit from visual aids, and thankfully, numerous free printable charts are readily available online. These charts typically illustrate key exercises, breaking down each movement into simple, step-by-step instructions.

You’ll find charts focusing on foundational Pilates principles – centering, concentration, control, precision, breath, and flow – alongside diagrams demonstrating proper form for exercises like The Hundred, Roll-Ups, and Single Leg Circles.
These resources are incredibly helpful for understanding correct alignment and engaging the correct muscles. Many PDFs include variations for different fitness levels, allowing you to progress gradually. Searching for “beginner Pilates chart PDF” will yield a wealth of options, often categorized by muscle group or exercise type, making it easy to find what you need to start your Pilates journey.
Beginner Pilates Workout PDFs
Pilates enthusiasts seeking structured routines will find a plethora of beginner workout PDFs online. These downloadable guides offer pre-designed sequences, eliminating the guesswork of creating your own program. Many PDFs cater specifically to those new to Pilates, emphasizing foundational movements and proper form.
Expect to find workouts ranging from 20 to 45 minutes, incorporating mat Pilates exercises like The Hundred, Roll-Ups, and Spine Stretch Forward. These PDFs often include modifications for varying fitness levels, ensuring accessibility for all.
Look for PDFs that provide clear instructions, visual cues, and tips on breathing techniques. Searching for “beginner Pilates workout PDF” will reveal numerous free and paid options, allowing you to choose a routine that aligns with your goals and preferences.
Comprehensive Pilates Guides (PDF)
For a deeper understanding of Pilates, consider downloading comprehensive guides in PDF format. These resources go beyond basic workout routines, delving into the history, principles, and benefits of the method. They often explain the importance of core engagement, spinal alignment, and breath control – crucial elements for safe and effective practice.
Expect detailed explanations of various Pilates exercises, accompanied by illustrations or photographs demonstrating proper form. These guides frequently cover modifications for different body types and fitness levels, making Pilates accessible to everyone.
Many PDFs also include information on Pilates equipment and how to incorporate it into your workouts. Searching for “Pilates guide PDF” will yield options ranging from introductory overviews to in-depth manuals.